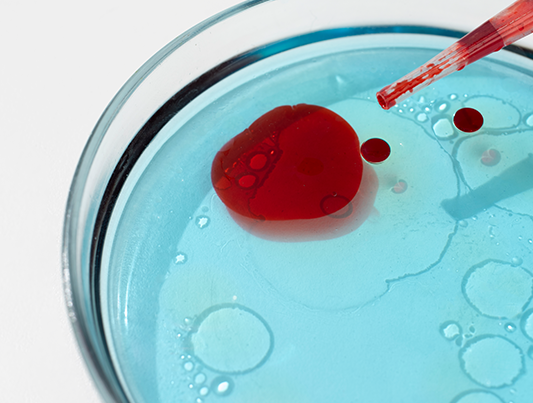

Анемія: причини, симптоми та поради щодо лікування
-
Зміст
- Симптоми анемії
- Різновиди анемії
- В чому небезпека для здоровʼя: наслідки анемії
- Як запобігти появі хвороби
Дата публікації: 11 лютого 2024
Симптоми анемії
Відчуття запаморочення, слабкість, сонливість, бліда шкіра — ми звикли списувати ці симптоми на втому, стрес і недосипання. Але часто ці ознаки можуть свідчити про анемію. Анемія — це стан, за якого знижується кількість гемоглобіну та еритроцитів (червоних кров’яних клітин) в одиниці об’єму крові. Діагностикою та лікуванням порушень роботи кровоносної системи займається гематолог. У Черкасах отримати консультацію цього спеціаліста і пройти обстеження можна в медцентрі “Авіцена”.
Гемоглобін — це безальтернативний переносник кисню до всіх клітин і тканин людського організму. При зниженні кількості гемоглобіну порушується транспортування кисню до всіх органів і систем.
Звідси й усі симптоми:
- слабкість і запаморочення, швидка стомлюваність і сонливість;
- мерзлякуватість, блідість шкіри, нігтів і слизових оболонок;
- миготіння перед очима, головний біль, шум у вухах;
- дискомфорт під час невеликої фізичної активності;
- порушення апетиту, менструального циклу, зниження лібідо;
- суха шкіра, порідіння волосся, ламкість нігтів;
- незвичні смакові пристрасті, наприклад, до крейди чи глини.
За легких форм хвороби симптоми можуть бути слабко або зовсім не вираженими: тіло адаптується до зниження гемоглобіну, тому ознаки можуть бути змазаними.
За критеріями ВООЗ, діагноз “анемія” ставлять за таких показників зниження концентрації гемоглобіну: в чоловіків — нижче за 130 г/л, у жінок — нижче ніж 120 г/л, у вагітних — нижче за 110 г/л.
Різновиди анемії
Існує вісім основних видів анемії, ми розглянемо найбільш поширені:
- залізодефіцитна (поширена серед дітей, у жінок репродуктивного віку повʼязана зі збоями менструального циклу та вагітністю);
- постгеморагічна (зʼявляється через хронічну або гостру кровотечу);
- В12-дефіцитна (виникає через погане всмоктування вітаміну В12 організмом);
- фолієводефіцитна (часто зʼявляється у жінок при надії, під час деяких запальних захворювань і хвороб крові).
Деякі види викликають легкі наслідки для здоровʼя, інші є загрозливими. Але в будь-якому випадку прийом гематолога — це перший крок до одужання й покращення самопочуття.
16
Задати питання
Причини появи анемії
Існує багато факторів, що можуть стати причиною розвитку цього захворювання. Кожен із них може спровокувати проблему, але здебільшого вони атакують одночасно.
Найбільш поширені причини появи анемії: незбалансоване харчування, хвороби, що заважають продукції еритроцитів у кістковому мозку, проблеми зі всмоктуванням мікроелементів і роботою ШКТ тощо.
Також симптоми можуть зʼявитися під час вагітності. Жінки при надії часто страждають від дефіциту деяких мікроелементів, зокрема заліза. Анемія часто проявляється у людей, які практикують голодування та відмову від білкової їжі. Подекуди недуга вражає професійних спортсменів із напруженим графіком тренувань.
В чому небезпека для здоровʼя: наслідки анемії
Головна небезпека полягає в тому, що за відсутності лікування анемія так чи інакше негативно впливатиме на функціонування всіх інших органів. З часом це призведе до погіршення самопочуття та може спровокувати появу складних захворювань.
Наслідки анемії, яку не лікують, можуть бути як легкими, так і досить серйозними. Так, у більшості людей настає синдром хронічної втоми з занепадом сил. Це той стан, коли важко встати з ліжка, й людина не відчуває сил навіть на елементарні побутові задачі. Ще одна небезпека криється в ослабленні імунного захисту організму через гіпоксію імунної системи. Це робить людей сприйнятливими до хронічних інфекцій.
Також без терапії хвороба підвищує ризик ускладнень серцево-судинної та респіраторної системи, можуть зʼявитися аритмії та серцева недостатність. На фоні анемії можливий розвиток синдрому неспокійних ніг — це пов’язано з ураженням нервової системи.
Записатись на процедуру
Діагностика анемії
Патологію не можна залишати без уваги. Діагностика анемії включає консультацію у гематолога, лабораторні аналізи та інструментальні обстеження, щоб встановити причину появи та розпочати корекцію.
Перелік потрібних обстежень та аналізів — індивідуальний для кожного пацієнта. Гематолог у Черкасах призначає їх з огляду на анамнез і клінічну картину.
Як запобігти появі хвороби
Профілактика анемії стосується організації режиму дня та дієти.
- Збагатіть раціон продуктами, що містять багато заліза. Це гречка, печінка, лосось, яловичина, креветки, курка, нут, квасоля, цільнозернова вівсяна крупа.
- Вживайте достатню кількість продуктів із вітаміном С, що сприяє кращому засвоєнню заліза. Це чорна смородина, петрушка, шпинат, броколі, капуста, ківі, лимон, апельсин, лічі, хурма.
- Зменшення споживання кави та міцного чаю — хороша профілактика анемії. Ці напої негативно позначаються на засвоєнні мікроелементів.
- Займайтеся спортом і багато гуляйте. Якщо відчуваєте в собі сили, запишіться на танці чи плавання. Якщо такі фізичні вправи не для вас, гуляйте на свіжому повітрі щонайменше 30-40 хвилин щодня. Стресові ситуації та недосипання також краще залишити в “минулому житті”.
- Дуже важливо уважно стежити за станом здоровʼя та регулярно проходити профогляди. А якщо у вас уже є ознаки недуги, якнайшвидше зверніться до гематолога для додаткового обстеження.
- Раз на рік проходьте консультацію гематолога, це допоможе виявити анемію й інші патологічні стани та вчасно розпочати лікування.
Виникли питання? Телефонуйте
098 469 85 78
